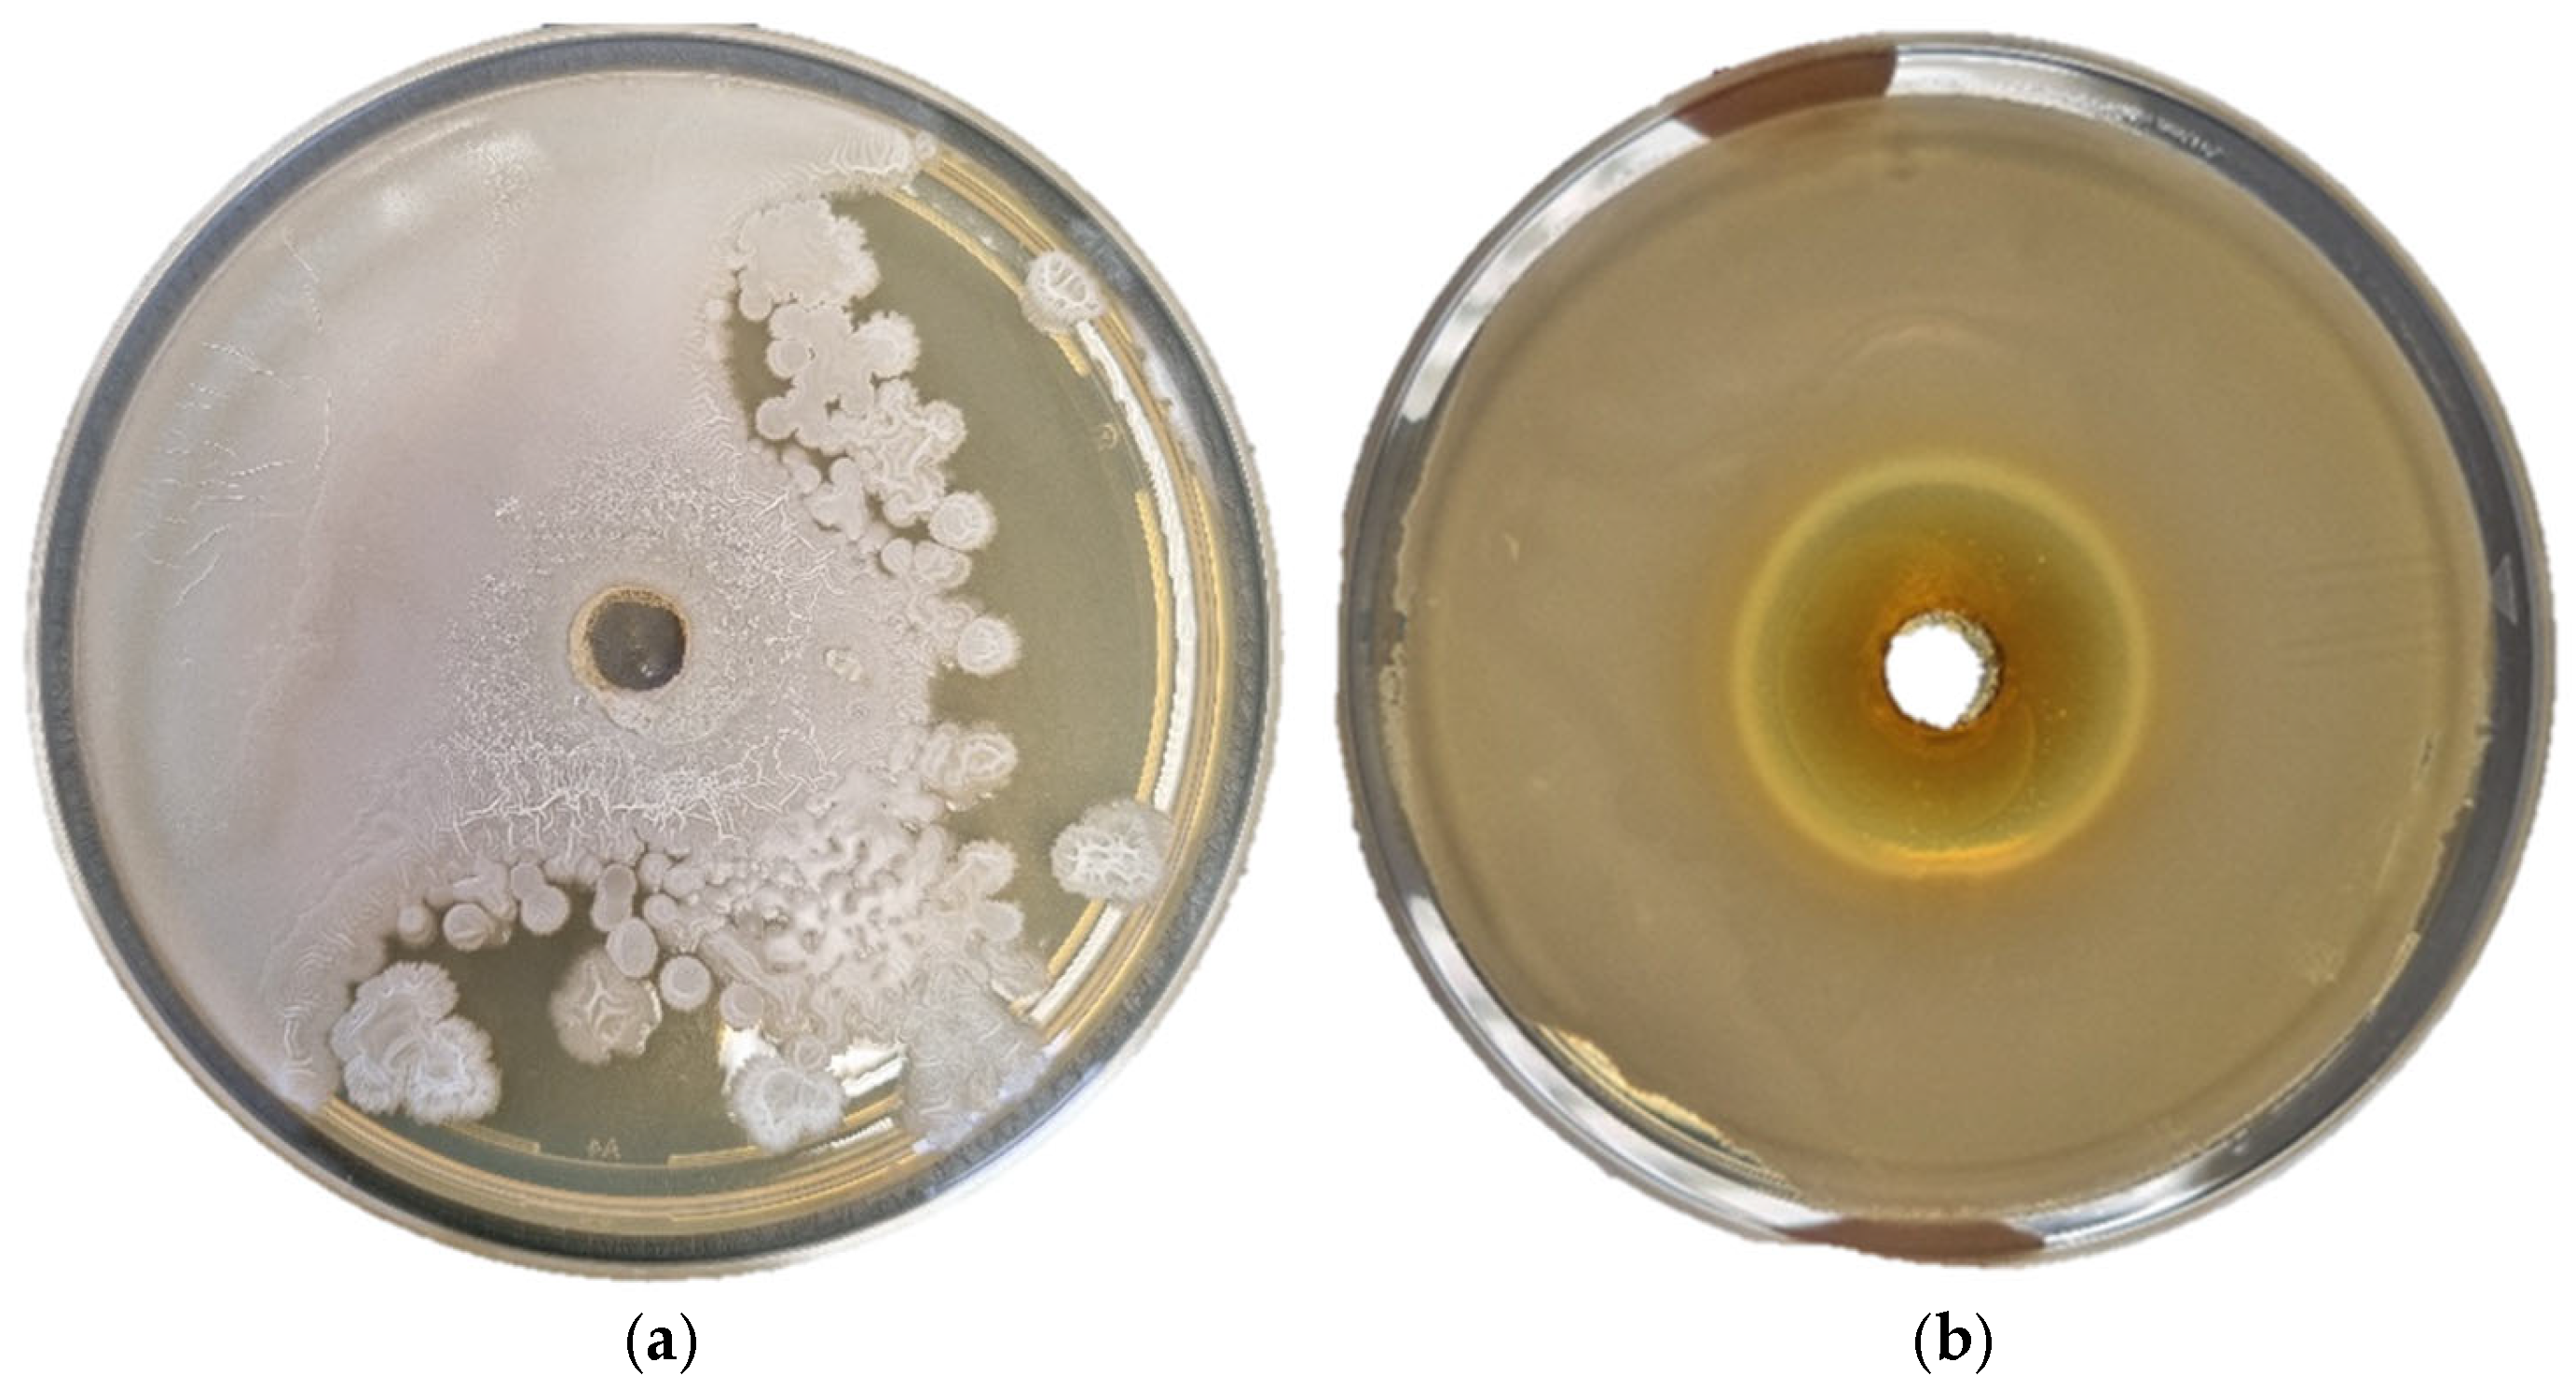
Antioxidants 14 00906 g004

Properties of Plant Extracts from Adriatic Maritime Zone for Innovative Food and Packaging Applications: Insights into Bioactive Profiles, Protective Effects, Antioxidant Potentials and Antimicrobial Activity
Abstract
1. Introduction
2. Materials and Methods
2.1. Materials
2.2. Methods
2.2.1. Preparation of Extracts—Microwave-Assisted Extraction
2.2.2. Spectrophotometric Analysis of Total Phenolic and Total Flavonoid Content
2.2.3. HPLC Analysis of Phenolic Compounds
2.2.4. Determination of Volatile Compounds via HS-SPME/GC–MS
2.2.5. Determination of Total Chlorophylls and Total Carotenoids
2.2.6. Determination of Antioxidant Activity Using DPPH and FRAP Method
2.2.7. Antimicrobial Activity
2.3. Statistical Analysis
3. Results and Discussion
3.1. Total Phenolic Content, Total Flavonoid Content and Detailed Chemical Profiles of Plant Extracts
3.1.1. Sea Fennel
3.1.2. Rosemary
3.1.3. Olive and Mock Privet
3.1.4. Lemon Balm
3.2. Total Chlorophylls and Total Carotenoids
3.3. Antioxidant Activity of Plant Extracts Determined Using DPPH and FRAP Method
3.4. Antimicrobial Activity
| Study (Reference) | Conditions | Antioxidant Activity–DPPH | Antioxidant Activity–FRAP | ||||||
|---|---|---|---|---|---|---|---|---|---|
| Sea Fennel Leaf | Sea Fennel Flower | Sea Fennel Leaf | Sea Fennel Flower | ||||||
| W | HA | W | HA | W | HA | W | HA | ||
| Present work | MAE, P/S 1:20, 500 W, 10 min | 44.81 ± 0.43% | 48.44 ± 0.26% | 84.38 ± 0.92% | 78.77 ± 0.60% | 105.77 ± 5.94 mgAAE/g | 55.16 ± 0.00 mgAAE/g | 219.67 ± 10.55 mgAAE/g | 96.83 ± 6.54 mgAAE/g |
| [31] | MAE, P/S 1:10, 500 W | x | x | x | x | x | 185.01 | x | x |
| [48] | Infusion, 1:20 | IC50 148–298 µg/mL | x | 310 | x | 48–67 | x | 70 μM Fe2+ | x |
| [98] | MAE, P/S 1:10, 30 min, 500 W | 29–36% | x | x | x | 12–14.36 mM Fe2+ | x | x | x |
| [99] | Infusion, P/S 1:25 | x | x | x | x | x | EC50 0.152 mg/mL | x | x |
| [100] | Sequiential extraction, P/S 1:10 | 81 | 132 µgTrolox/mg | x | 60 | 147 | 231 µgTrolox Eq/mg | 122 | 232 |
| Rosemary | |||||||||
| W | HA | W | HA | ||||||
| Present work | 67.62 ± 3.24% | 16.83 ± 0.34% | 57.25 ± 0.66 mgAAE/g | 52.33 ± 0.00 mgAAE/g | |||||
| [60] | Conv., 50:50 E:W, 24 h | x | 20.6 ± 1.1 µg/mL | x | x | ||||
| MAE, 50:50 E:W, 50 °C, 1 h | x | 19.2 ± 0.7 µg/mL | x | x | |||||
| [63] | Stirring extraction | x | 110.1 ± 6.61 µmolAAE/g | x | 161.95 ± 3.56 µmolAAE/g | ||||
| UAE | x | 97.96 ± 3.33 µmolAAE/g | x | 127.69 ± 6.51 µmolAAE/g | |||||
| [101] | Maceration | 1.04 ± 0.06 mgBHT/mL | x | 0.52 ± 0.05 mg FeSO4 × 7 H2O/mL | x | ||||
| [102] | Conv. Ex., 16 h | 105 mgGAE/g | x | 125 mgAsc/g | x | ||||
| [59] | Conv. Ex., 70 °C, 30 min | x | 4745.72 ± 0.47 µmolTE/g | x | 180.09 ± 0.01 µmol Fe2+/g | ||||
| Olive | |||||||||
| Present work | 67.89 ± 130% | 9.78 ± 0.51% | 38.62 ± 0.42 mgAAE/g | 50.45 ± 0.69 mgAAE/g | |||||
| [91] | Conv. Ex., 24 h | 7.48 ± 0.39 μg/mL | 10.88 ± 0.22 μg/mL | 153.72 ± 2.70 mgAAE/g | 258.76 ± 6.69 mgAAE/g | ||||
| [103] | Conv. Ex., 60 °C, 15 min | 0.65 ± 0.09 mmol FeSO4 × 7 H2O/mL | x | 0.28 ± 0.00 mmolTrolox/g | x | ||||
| MAE, 400 W, 60 °C, 5 min | 0.83 ± 0.08 mmol FeSO4 × 7 H2O/mL | x | 0.39 ± 0.08 mmolTrolox/g | x | |||||
| Mock privet | |||||||||
| Present work | 21.78 ± 1.51% | 13.31 ±0.15% | 37.33 ± 2.65 mgAAE/g | 74.95 ± 0.08 mgAAE/g | |||||
| [37] | UAE 30 min, 30 °C | x | 111.92 ± 1.38 mgTE/g | x | 60.92 ± 0.24 mgTE/g | ||||
| MAE, 30 min, 40 °C | x | 102.56 ± 0.65 mgTE/g | x | 53.60 ± 0.45 mgTE/g | |||||
| [104] | Electrothermal heating ex., 70 °C | x | 62.48 ± 3.71 IC50 µg/mL | x | 32.66 ± 4.27 mgTE/g | ||||
| [105] | Conv. Ex. | x | IC50 29.0 µg/mL | x | x | ||||
| Lemon balm | |||||||||
| Present work | 50.89 ±3.85% | 55.63 ± 0.37% | 142.44 ± 5.42 mgAAE/g | 224.34 ± 6.00 mgAAE/g | |||||
| [88] | Extraction in an oven at 40 °C for 24 h | IC50 62.83 ± 0.80 µg/mL | x | x | 250.39 ± 38.80 µmolTrolox/L | ||||
| [106] | Extraction uder reflux of solvent, 2.5 h | IC50 4.91 ± 0.49 | IC50 4.76 ± 0.48 | 329.06 ± 23.75 mgAAE/g | 294.39 ± 11.67 mgAAE/g | ||||
| [107] | UAE, 540 W, 4 min, 50 °C | 2006.9 ± 83.5 µmolTE/g | x | x | x | ||||
| [108] | UAE, 2 min, 30 °C | 470 mgGAE/g | x | x | 680 mgGAE/g | ||||
| [109] | Water bath extraction for 10 h, 45 °C | 0.58 ± 0.01 mmolTE/g extract | x | x | 0.26 ± 0.01 mmol TE/g extract | ||||
| Microorganisms | Sea Fennel Leaf | Sea Fennel Flower | Rosemary | Olive | Mock Privet | Lemon Balm |
|---|---|---|---|---|---|---|
| Zone of Inhibition in mm (Mean ± SE) | ||||||
| V. fisheri | 24.0 ± 0.3 | / | 18.0 ± 0.3 | 25.0 ± 0.1 | 21.0 ± 0.1 | 30.0 ± 0.2 |
| V. alginolyticus | / | / | / | 13.0 ± 0.2 | 17.0 ± 0.1 | / |
| M. lacunata | / | 14.5 ± 0.3 | / | 28.0 ± 0.1 | 30.0 ± 0.2 | / |
| Y. ruckeri | / | / | / | / | / | / |
| P. aeruginosa | / | / | / | / | / | / |
| A. hydrophila | / | 20.0 ± 0.1 | / | 26.0 ± 0.1 | 15.0 ± 0.2 | / |
4. Conclusions
Supplementary Materials
Author Contributions
Funding
Institutional Review Board Statement
Informed Consent Statement
Data Availability Statement
Acknowledgments
Conflicts of Interest
References
- Facchini, F.; Silvestri, B.; Digiesi, S.; Lucchese, A. Agri-Food Loss and Waste Management: Win-Win Strategies for Edible Discarded Fruits and Vegetables Sustainable Reuse. IFSET 2023, 83, 103235. [Google Scholar] [CrossRef]
- Dermeche, S.; Mezoued, K.; Naib, H.; Senani, N.; Chaouche, T.A.; Alenazy, R.; Alhussaini, M.S.; Abdulrahman, A.; Alqasmi, M.; Almufarriji, F.M.; et al. Olive Tree Twigs as an Attractive Green Source of Antioxidant and Antibiofilm Biomolecules. Processes 2025, 13, 559. [Google Scholar] [CrossRef]
- Cui, J.; Li, X.; Lu, Z.; Jin, B. Plant Secondary Metabolites Involved in the Stress Tolerance of Long-Lived Trees. Tree Physiol. 2024, 44, tpae002. [Google Scholar] [CrossRef] [PubMed]
- Popović, M.; Radman, S.; Generalić Mekinić, I.; Ninčević Runjić, T.; Urlić, B.; Veršić Bratinčević, M. A Year in the Life of Sea Fennel: Annual Phytochemical Variations of Major Bioactive Secondary Metabolites. Appl. Sci. 2024, 14, 3440. [Google Scholar] [CrossRef]
- La Scala, S.; Naselli, F.; Quatrini, P.; Gallo, G.; Caradonna, F. Drought-Adapted Mediterranean Diet Plants: A Source of Bioactive Molecules Able to Give Nutrigenomic Effects per Sè or to Obtain Functional Foods. Int. J. Mol. Sci. 2024, 25, 2235. [Google Scholar] [CrossRef] [PubMed]
- Asif, M. Chemistry and Antioxidant Activity of Plants Containing Some Phenolic Compounds. Int. Sci. Org. J. 2015, 1, 35–52. [Google Scholar]
- Capanoglu, E.; Nemli, E.; Tomas-Barberan, F. Novel Approaches in the Valorization of Agricultural Wastes and Their Applications. J. Agric. Food Chem. 2022, 70, 6787–6804. [Google Scholar] [CrossRef]
- Grigore-Gurgu, L.; Dumitrașcu, L.; Aprodu, I. Aromatic Herbs as a Source of Bioactive Compounds: An Overview of Their Antioxidant Capacity, Antimicrobial Activity, and Major Applications. Molecules 2025, 30, 1304. [Google Scholar] [CrossRef]
- Periyasamy, T.; Asrafali, S.P.; Lee, J. Recent Advances in Functional Biopolymer Films with Antimicrobial and Antioxidant Properties for Enhanced Food Packaging. Polymers 2025, 17, 1257. [Google Scholar] [CrossRef]
- Ninčević Runjić, T.; Jug-Dujaković, M.; Runjić, M.; Łuczaj, Ł. Wild Edible Plants Used in Dalmatian Zagora (Croatia). Plants 2024, 13, 1079. [Google Scholar] [CrossRef]
- Walait, M.; Mir, H.R.; Anees, K. Edible Biofilms and Coatings; Its Characterization and Advanced Industrial Applications. Nat. Resour. Hum. Health 2023, 3, 28–37. [Google Scholar] [CrossRef]
- Gürdal, A.A.; Çetinkaya, T. Advancements in Edible Films for Aquatic Product Preservation and Packaging. Rev. Aquac. 2024, 16, 997–1020. [Google Scholar] [CrossRef]
- Benbettaieb, N. Active and Intelligent Packaging. In Packaging Materials and Processing for Food, Pharmaceuticals and Cosmetics; Debeaufort, F., Galić, K., Kurek, M., Benbettaieb, N., Ščetar, M., Eds.; John Wiley and Sons: New York, NY, USA, 2021; pp. 183–218. ISBN 978-1-119-82507-4. [Google Scholar]
- Rico, D.; Albertos, I.; Martinez-Alvarez, O.; Elvira Lopez-Caballero, M.; Martin-Diana, A.B. Use of Sea Fennel as a Natural Ingredient of Edible Films for Extending the Shelf Life of Fresh Fish Burgers. Molecules 2020, 25, 5260. [Google Scholar] [CrossRef] [PubMed]
- Orhotohwo, O.L.; Nartea, A.; Lucci, P.; Jaiswal, A.K.; Jaiswal, S.; Pacetti, D. Application of Sea Fennel’s Bioactive Compounds in the Development of Edible Films and Coatings: A Review. Food Biosci. 2024, 61, 104843. [Google Scholar] [CrossRef]
- Generalić Mekinić, I.; Politeo, O.; Ljubenkov, I.; Mastelić, L.; Popović, M.; Veršić Bratinčević, M.; Šimat, V.; Radman, S.; Skroza, D.; Ninčević Runjić, T.; et al. The Alphabet of Sea Fennel: Comprehensive Phytochemical Characterisation of Croatian Populations of Crithmum maritimum L. Food Chem. X 2024, 22, 101386. [Google Scholar] [CrossRef]
- Politeo, O.; Ćurlin, P.; Brzović, P.; Auzende, K.; Magné, C.; Generalić Mekinić, I. Volatiles from French and Croatian Sea Fennel Ecotypes: Chemical Profiles and the Antioxidant, Antimicrobial and Antiageing Activity of Essential Oils and Hydrolates. Foods 2024, 13, 695. [Google Scholar] [CrossRef]
- Radman, S.; Mastelić, L.; Ljubenkov, I.; Lazarevski, S.; Politeo, O.; Podrug, R.; Prga, I.; Čorić, I.; Popović, M.; Veršić Bratinčević, M.; et al. Sea Fennel (Crithmum maritimum L.) Flowers as an Emerging Source of Bioactive Compounds. Pol. J. Food Nutr. Sci. 2024, 74, 221–231. [Google Scholar] [CrossRef]
- Slišković, L.; Režić Mužinić, N.; Politeo, O.; Brzović, P.; Tomaš, J.; Generalić Mekinić, I.; Popović, M. Biological Activities of Essential Oils and Hydrolates from Different Parts of Croatian Sea Fennel (Crithmum maritimum L.). Biomolecules 2025, 15, 666. [Google Scholar] [CrossRef]
- Munekata, P.E.; Alcántara, C.; Žugčić, T.; Abdelkebir, R.; Collado, M.C.; García-Pérez, J.V.; Jambrak, A.R.; Gavahian, M.; Barba, F.J.; Lorenzo, J.M. Impact of Ultrasound-Assisted Extraction and Solvent Composition on Bioactive Compounds and in Vitro Biological Activities of Thyme and Rosemary. Food Res. Int. 2020, 134, 109242. [Google Scholar] [CrossRef]
- Ziani, I.; Bouakline, H.; Merzouki, M.; Fauconnier, M.L.; Sher, F.; Bentouhami, N.E.; Asehraou, A.; El Bachiri, A. Purification of Bioactive Compounds from Rosemary By-Products for Innovative Solutions in Food Industry. Ind. Crop. Prod. 2025, 223, 120125. [Google Scholar] [CrossRef]
- de Oliveira, N.M.; Machado, J.; Chéu, M.H.; Lopes, L.; Criado, M.B. Therapeutic Potential of Olive Leaf Extracts: A Comprehensive Review. Appl. Biosci. 2024, 3, 392–425. [Google Scholar] [CrossRef]
- da Rosa, G.S.; Martiny, T.R.; Dotto, G.L.; Vanga, S.K.; Parrine, D.; Gariepy, Y.; Lefsrud, M.; Raghavan, V. Eco-Friendly Extraction for the Recovery of Bioactive Compounds from Brazilian Olive Leaves. Sustain. Mater. Technol. 2021, 28, e00276. [Google Scholar] [CrossRef]
- Boli, E.; Prinos, N.; Louli, V.; Pappa, G.; Stamatis, H.; Magoulas, K.; Voutsas, E. Recovery of Bioactive Extracts from Olive Leaves Using Conventional and Microwave-Assisted Extraction with Classical and Deep Eutectic Solvents. Separations 2022, 9, 255. [Google Scholar] [CrossRef]
- Mushtaq, H.; Piccolella, S.; Mendiola, J.A.; Montero, L.; Ibáñez, E.; Pacifico, S. Recovery of Bioactive Constituents from Olive Leaf Pruning Waste of Five Different Cultivars: A Comparison of Green Extraction Techniques to Maximize Health Benefits. Foods 2025, 14, 297. [Google Scholar] [CrossRef]
- Aydin, E. Phytochemicals from Phillyrea latifolia L. Leaves and Fruit Extracted with Various Solvents: Their Identification and Quantification by LC-MS and Antihyperglycemic Effects. Folia Hortic. 2023, 35, 233–242. [Google Scholar] [CrossRef]
- Baranauskaite, J.; Oçkun, M.A. Preparation and Characterization of Electrospun Polyvinylpyrrolidone Nanofiber Mat Containing Phillyrea latifolia L. Herbal Extract and Evaluation of Antioxidant Mechanism. J. Pharm. Innov. 2024, 19, 59. [Google Scholar] [CrossRef]
- Dallali, S.; Riguene, H.; Fkiri, S.; Toumi, L.; Canela–garayoa, R.; Salem, R.B.; Rigane, G.; Ghazghazi, H.; Eras, J. Pistacia lentiscus L., Phillyrea latifolia L., Globularia alypum L. and Ceratonia siliqua L.: UPLC-PDA-MS-TQ Analysis of the Phenolic Content Leaves’ in Relation to Their Growing Area. Rev. Roum. Chim. 2025, 70, 43–52. [Google Scholar] [CrossRef]
- Simić, S.; Vidović, S.; Lubura Stošić, J.; Filipović, K.; Aladić, K.; Jokić, S.; Gavarić, A. Utilizing Herbal Dust: Ultrasound-Assisted Extraction of Green Tea, Hibiscus, and Lemon Balm Filter Tea Industry Waste. Processes 2024, 12, 2405. [Google Scholar] [CrossRef]
- Žlabur, J.Š.; Voća, S.; Dobričević, N.; Pliestić, S.; Galić, A.; Boričević, A.; Borić, N. Ultrasound-Assisted Extraction of Bioactive Compounds from Lemon Balm and Peppermint Leaves. Int. Agrophysics 2016, 30, 95–104. [Google Scholar] [CrossRef]
- Veršić Bratinčević, M.; Kovačić, R.; Popović, M.; Radman, S.; Generalić Mekinić, I. Comparison of Conventional and Green Extraction Techniques for the Isolation of Phenolic Antioxidants from Sea Fennel. Processes 2023, 11, 2172. [Google Scholar] [CrossRef]
- El Maabiche, O.; Benkirane, C.; Abid, M.; Serghini-Caid, H.; Elamrani, A.; Mansouri, F. Sustainable Extraction of Bioactive Compounds from Plant Materials: Advances in Green Technologies and Solvent Systems. In Green Chemistry, Sustainable Processes, and Technologies; IGI Global: Hershey, PA, USA, 2025; pp. 433–463. ISBN 9798369398289. [Google Scholar]
- Sokač Cvetnić, T.; Krog, K.; Benković, M.; Jurina, T.; Valinger, D.; Gajdoš Kljusurić, J.; Radojčić Redovniković, I.; Jurinjak Tušek, A. Solid–Liquid Extraction of Bioactive Molecules from White Grape Skin: Optimization and Near-Infrared Spectroscopy. Separations 2023, 10, 452. [Google Scholar] [CrossRef]
- Lee, J.E.; Jayakody, J.T.M.; Kim, J.I.; Jeong, J.W.; Choi, K.M.; Kim, T.S.; Seo, C.; Azimi, I.; Hyun, J.M.; Ryu, B.M. The Influence of Solvent Choice on the Extraction of Bioactive Compounds from Asteraceae: A Comparative Review. Foods 2024, 13, 3151. [Google Scholar] [CrossRef]
- Lee, E.J.; Yoon, K.Y. Optimization of Deep Eutectic Solvent-Based Ultrasound-Assisted Extraction of Bioactive Compounds from Maca Leaves Using the Taguchi Method. Molecules 2025, 30, 1635. [Google Scholar] [CrossRef] [PubMed]
- Sánchez-Gutiérrez, M.; Bascón-Villegas, I.; Rodríguez, A.; Pérez-Rodríguez, F.; Fernández-Prior, Á.; Rosal, A.; Carrasco, E. Article Valorisation of Olea europaea L. Olive Leaves through the Evaluation of Their Extracts: Antioxidant and Antimicrobial Activity. Foods 2021, 10, 966. [Google Scholar] [CrossRef] [PubMed]
- Irakli, M.; Samara, T.; Bouloumpasi, E.; Kadoglidou, K.; Chatzopoulou, P.; Spanos, I. Valuable Nutrients, Aroma Profile, and Functional Bioactives Extracted by Eco-Friendly Extraction Techniques from Wild Olive Fruits (Olea europaea L. Var. sylvestris). Processes 2024, 12, 1181. [Google Scholar] [CrossRef]
- Hashempur, M.H.; Zareshahrabadi, Z.; Shenavari, S.; Zomorodian, K.; Rastegari, B.; Karami, F. Deep Eutectic Solvent-Based Extraction of Rosemary Leaves: Optimization Using Central Composite Design and Evaluation of Antioxidant and Antimicrobial Activities. New J. Chem. 2025, 49, 4495–4505. [Google Scholar] [CrossRef]
- Hamieau, M.; Loulergue, P.; Szydłowska-Czerniak, A. Green Solvent Extraction of Antioxidants from Herbs and Agro-Food Wastes: Optimization and Capacity Determination. Appl. Sci. 2024, 14, 2936. [Google Scholar] [CrossRef]
- Shortle, E.; O’Grady, M.N.; Gilroy, D.; Furey, A.; Quinn, N.; Kerry, J.P. Influence of Extraction Technique on the Anti-Oxidative Potential of Hawthorn (Crataegus monogyna) Extracts in Bovine Muscle Homogenates. Meat Sci. 2014, 98, 828–834. [Google Scholar] [CrossRef]
- Chang, C.-C.; Yang, M.-H.; Wen, H.-M.; Chern, J.-C. Estimation of Total Flavonoid Content in Propolis by Two Complementary Colorimetric Methods. J. Food Drug Anal. 2002, 10, 178–182. [Google Scholar] [CrossRef]
- Holm, G. Chlorophyll Mutations in Barley. Acta Agric. Scand. 1954, 4, 457–471. [Google Scholar] [CrossRef]
- Van Wettstein, D.; Forschungsanstalt, F. Chlorophyll-letale und der submikroskopische formwechsel der plastiden. Exp. Cell Res. 1957, 3, 427–506. [Google Scholar] [CrossRef] [PubMed]
- Hossain, T.J. Methods for Screening and Evaluation of Antimicrobial Activity: A Review of Protocols, Advantages, and Limitations. Eur. J. Microbiol. Immunol. 2024, 14, 97–115. [Google Scholar] [CrossRef] [PubMed]
- Pérez, M.; Dominguez-López, I.; Lamuela-Raventós, R.M. The Chemistry Behind the Folin-Ciocalteu Method for the Estimation of (Poly)Phenol Content in Food: Total Phenolic Intake in a Mediterranean Dietary Pattern. J. Agric. Food Chem. 2023, 71, 17543–17553. [Google Scholar] [CrossRef] [PubMed]
- Samara, M.; Nasser, A.; Mingelgrin, U. Critical Examination of the Suitability of the Folin-Ciocalteu Reagent Assay for Quantitative Analysis of Polyphenols—The Case of Olive-Mill Wastewater. Am. J. Analyt Chem. 2022, 13, 476–493. [Google Scholar] [CrossRef]
- Šimat, V.; Skroza, D.; Tabanelli, G.; Čagalj, M.; Pasini, F.; Gómez-Caravaca, A.M.; Fernández-Fernández, C.; Sterniša, M.; Smole Možina, S.; Ozogul, Y.; et al. Antioxidant and Antimicrobial Activity of Hydroethanolic Leaf Extracts from Six Mediterranean Olive Cultivars. Antioxidants 2022, 11, 1656. [Google Scholar] [CrossRef]
- Nartea, A.; Orhotohwo, O.L.; Fanesi, B.; Lucci, P.; Loizzo, M.R.; Tundis, R.; Aquilanti, L.; Casavecchia, S.; Quattrini, G.; Pacetti, D. Sea Fennel (Crithmum maritimum L.) Leaves and Flowers: Bioactive Compounds, Antioxidant Activity and Hypoglycaemic Potential. Food Biosci. 2023, 56, 103417. [Google Scholar] [CrossRef]
- Kraouia, M.; Nartea, A.; Maoloni, A.; Osimani, A.; Garofalo, C.; Fanesi, B.; Ismaiel, L.; Aquilanti, L.; Pacetti, D. Sea Fennel (Crithmum maritimum L.) as an Emerging Crop for the Manufacturing of Innovative Foods and Nutraceuticals. Molecules 2023, 28, 4741. [Google Scholar] [CrossRef]
- Jibhkate, Y.J.; Awachat, A.P.; Lohiya, R.; Umekar, M.J.; Hemke, A.T.; Gupta, K.R. Extraction: An important tool in the pharmaceutical field. Int. J. Sci. Res. Arch. 2023, 10, 555–568. [Google Scholar] [CrossRef]
- Abarca-Vargas, R.; Petricevich, V.L. Comparison of Different Extraction Methods for the Phenolic Compounds Recovery with the Antioxidant Activity of Bougainvillea x buttiana. Curr. Anal. Chem. 2020, 16, 778–787. [Google Scholar] [CrossRef]
- Galanakis, C.M.; Goulas, V.; Tsakona, S.; Manganaris, G.A.; Gekas, V. A Knowledge Base for the Recovery of Natural Phenols with Different Solvents. Int. J. Food Prop. 2013, 16, 382–396. [Google Scholar] [CrossRef]
- Souid, A.; Della Croce, C.M.; Frassinetti, S.; Gabriele, M.; Pozzo, L.; Ciardi, M.; Abdelly, C.; Hamed, K.B.; Magné, C.; Longo, V. Nutraceutical Potential of Leaf Hydro-Ethanolic Extract of the Edible Halophyte Crithmum maritimum L. Molecules 2021, 26, 5380. [Google Scholar] [CrossRef] [PubMed]
- Giungato, P.; Renna, M.; Rana, R.; Licen, S.; Barbieri, P. Characterization of Dried and Freeze-Dried Sea Fennel (Crithmum maritimum L.) Samples with Headspace Gas-Chromatography/Mass Spectrometry and Evaluation of an Electronic Nose Discrimination Potential. Food Res. Int. 2019, 115, 65–72. [Google Scholar] [CrossRef] [PubMed]
- Porrello, A.; Vaglica, A.; Savoca, D.; Bruno, M.; Sottile, F. Variability in Crithmum maritimum L. Essential Oils’ Chemical Composition: PCA Analysis, Food Safety, and Sustainability. Sustainability 2024, 16, 2541. [Google Scholar] [CrossRef]
- Pavela, R.; Maggi, F.; Lupidi, G.; Cianfaglione, K.; Dauvergne, X.; Bruno, M.; Benelli, G. Efficacy of Sea Fennel (Crithmum maritimum L.; Apiaceae) Essential Oils against Culex quinquefasciatus Say and Spodoptera littoralis (Boisd.). Ind. Crops Prod. 2017, 109, 603–610. [Google Scholar] [CrossRef]
- Škugor Rončević, I.; Buzuk, M.; Dugeč, J.; Franjić, T.; Vladislavić, N. Modeling of Microwave Extraction of Total Phenols and Antioxidant Activity of Rosemary (Rosmarinus officinalis L.). Croat. Chem. Acta 2025, 98, P1–P9. [Google Scholar] [CrossRef]
- Nguyen-Kim, M.T.; Truong, Q.C.; Nguyen, M.T.; Cao-Thi, B.H.; Tong, T.D.; Dao, T.P.; Tran, T.H.; Van Tan, L.; Le, X.T. Optimized Extraction of Polyphenols from Leaves of Rosemary (Rosmarinus officinalis L.) Grown in Lam Dong Province, Vietnam, and Evaluation of Their Antioxidant Capacity. Open Chem. 2021, 19, 1043–1051. [Google Scholar] [CrossRef]
- Bianchin, M.; Pereira, D.; Almeida, J.d.F.; de Moura, C.; Pinheiro, R.S.; Heldt, L.F.S.; Haminiuk, C.W.I.; Carpes, S.T. Antioxidant Properties of Lyophilized Rosemary and Sage Extracts and Its Effect to Prevent Lipid Oxidation in Poultry Pátê. Molecules 2020, 25, 5160. [Google Scholar] [CrossRef]
- Pontillo, A.R.N.; Papakosta-Tsigkri, L.; Lymperopoulou, T.; Mamma, D.; Kekos, D.; Detsi, A. Conventional and Enzyme-Assisted Extraction of Rosemary Leaves (Rosmarinus officinalis L.) Toward a Greener Approach to High Added-Value Extracts. Appl. Sci. 2021, 11, 3724. [Google Scholar] [CrossRef]
- Abo-Elmaaty, M.F.; Gedamy, G.M.; Awad, A.; El-Maghraby, L.M.M. Chemical Characterization of Rosmarinus Officinalis L. Hydrodistillation By-Products, Evaluating Their Antioxidant, and Anticancer Activities. Egypt. J. Chem. 2024, 4, 369–379. [Google Scholar] [CrossRef]
- Gonzalez-Rivera, J.; Campanella, B.; Pulidori, E.; Bramanti, E.; Tiné, M.R.; Bernazzani, L.; Onor, M.; Bàrberi, P.; Duce, C.; Ferrari, C. From Volatiles to Solid Wastes: Towards the Full Valorization of Lavender and Rosemary by Simultaneous in Situ Microwaves and Ultrasounds Irradiation Extraction. Ind. Crop. Prod. 2023, 194, 116362. [Google Scholar] [CrossRef]
- Athanasiadis, V.; Chatzimitakos, T.; Mantiniotou, M.; Kalompatsios, D.; Kotsou, K.; Makrygiannis, I.; Bozinou, E.; Lalas, S.I. Optimization of Four Different Rosemary Extraction Techniques Using Plackett–Burman Design and Comparison of Their Antioxidant Compounds. Int. J. Mol. Sci. 2024, 25, 7708. [Google Scholar] [CrossRef]
- Sharma, Y.; Schaefer, J.; Streicher, C.; Stimson, J.; Fagan, J. Qualitative Analysis of Essential Oil from French and Italian Varieties of Rosemary (Rosmarinus officinalis L.) Grown in the Midwestern United States. Anal. Chem. Lett. 2020, 10, 104–112. [Google Scholar] [CrossRef]
- Al Samer, A.J.; Al Samarrai, O.R. Phytochemical Screening, Antioxidant Power and Quantitative Analysis by HPLC of Isolated Flavonoids from Rosemary. Samarra J. Pure Appl. Sci. 2024, 6, 15–29. [Google Scholar] [CrossRef]
- Rafya, M.; Zehhar, N.; Hafidi, A.; Benkhalti, F. Review of Rosmarinus officinalis L. Essential Oil, Hydrosol, and Residues Analysis: Composition, Bioactivities, and Valorization. Ind. Crops Prod. 2024, 221, 119392. [Google Scholar] [CrossRef]
- Cukrov, M.; Žurga, P.; Germek, V.M.; Brkljača Dean Ban, M.; Lukić, I.; Goreta Ban, S.; Pasković, I. Effect of Olive (Olea europaea L.) Variety on Leaf Biophenolic Profile. Agric. Conspec. Sci. 2021, 86, 277–282. [Google Scholar]
- Debib, A.; Boukhatem, M.N. Phenolic Content, Antioxidant and Antimicrobial Activities of “Chemlali” Olive Leaf (Olea europaea L.) Extracts. Int. J. Pharmacol. Phytochem. Ethnomed. 2017, 6, 38–46. [Google Scholar] [CrossRef]
- Yateem, H.; Afaneh, I.; Al-Rimawi, F. Optimum Conditions for Oleuropein Extraction from Olive Leaves. Int. J. Appl. Sci. Technol. 2014, 4, 153–157. [Google Scholar]
- Gümüşbulut, G. Extraction of Oleuropein from Olive Leaves. Master’s Thesis, Izmir Institute of Technology, Izmir, Turkey, 2020. [Google Scholar]
- Romero-Díez, R.; Rodríguez-Rojo, S.; Cocero, M.J.; Duarte, C.M.M.; Matias, A.A.; Bronze, M.R. Phenolic Characterization of Aging Wine Lees: Correlation with Antioxidant Activities. Food Chem. 2018, 259, 188–195. [Google Scholar] [CrossRef] [PubMed]
- Wang, W.; Li, J.; Zhang, H.; Wang, X.; Fan, J.; Zhang, X. Phenolic Compounds and Bioactivity Evaluation of Aqueous and Methanol Extracts of Allium mongolicum Regel. Food Sci. Nutr. 2019, 7, 779–787. [Google Scholar] [CrossRef]
- Chiara Di Meo, M.; Izzo, F.; Rocco, M.; Zarrelli, A.; Mercurio, M.; Varricchio, E. Mid-Infrared Spectroscopic Characterization: New Insights on Bioactive Molecules of Olea europaea L. Leaves from Selected Italian Cultivars. Infrared Phys. Technol. 2022, 127, 104439. [Google Scholar] [CrossRef]
- Can, A.; Ayvaz, H.; Pala, Ç.U.; Condelli, N.; Galgano, F.; Tolve, R. The Potential of near and Mid-Infrared Spectroscopy for Rapid Quantification of Oleuropein, Total Phenolics, Total Flavonoids and Antioxidant Activity in Olive Tree (Olea europaea) Leaves. J. Food Meas. Charact. 2018, 12, 2747–2757. [Google Scholar] [CrossRef]
- Naija, D.S.; Gueddes, S.B.M.; Flamini, G.; Khiareddine, H.J.; Remadi, M.D.; Mariem, F.B.; Ghariani, W.; Braham, M. Assessment of Antioxidant and Antimicrobial Compounds of Volatiles from Leaves, Stems and Flowers of Olives. Pol. J. Environ. Stud. 2021, 30, 1325–1338. [Google Scholar] [CrossRef]
- Pashtetskaia, A.V.; Belous, O.G.; Bekhterev, V.N.; Shevchuk, O.M. Composition of Fatty Acids and Volatile Substances in the Leaves of Olea europaea L. In Proceedings of the BIO Web of Conferences; EDP Sciences: Les Ulis, France, 2024; Volume 141. [Google Scholar]
- Jaimez Ordaz, J.; Martínez Hernández, J.; Ramírez-Godínez, J.; Castañeda-Ovando, A.; Guillermo González-Olivares, L.; Contreras-López, E. Bioactive Compounds in Aqueous Extracts of Lemon Balm (Melissa officinalis) Cultivated in Mexico. Arch. Latinoam. Nutr. 2018, 68, 268–279. [Google Scholar] [CrossRef]
- Sentkowska, A.; Biesaga, M.; Pyrzynska, K. Polyphenolic Composition and Antioxidative Properties of Lemon Balm (Melissa officinalis L.) Extract Affected by Different Brewing Processes. Int. J. Food Prop. 2015, 18, 2009–2014. [Google Scholar] [CrossRef]
- Binello, A.; Cravotto, G.; Boffa, L.; Stevanato, L.; Bellumori, M.; Innocenti, M.; Mulinacci, N. Efficient and Selective Green Extraction of Polyphenols from Lemon Balm. Comptes Rendus Chim. 2017, 20, 921–926. [Google Scholar] [CrossRef]
- Nurzyńska-Wierdak, R.; Bogucka-Kocka, A.; Szymczak, G. Volatile Constituents of Melissa officinalis Leaves Determined by Plant Age. Nat. Prod. Commun. 2014, 9, 703–706. [Google Scholar] [CrossRef] [PubMed]
- Sousa, G.; Alves, M.I.; Neves, M.; Tecelão, C.; Ferreira-Dias, S. Enrichment of Sunflower Oil with Ultrasound-Assisted Extracted Bioactive Compounds from Crithmum maritimum L. Foods 2022, 11, 439. [Google Scholar] [CrossRef]
- Guil-Guerrero, J.L.; Rodríguez-García, I. Lipids Classes, Fatty Acids and Carotenes of the Leaves of Six Edible Wild Plants. Eur. Food Res. Technol. 1999, 209, 313–316. [Google Scholar] [CrossRef]
- Nabet, N.; Boudries, H.; Chougui, N.; Loupassaki, S.; Souagui, S.; Burló, F.; Hernández, F.; Carbonell-Barrachina, Á.A.; Madani, K.; Larbat, R. Biological Activities and Secondary Compound Composition from Crithmum maritimum Aerial Parts. Int. J. Food Prop. 2017, 20, 1843–1855. [Google Scholar] [CrossRef]
- Labiad, M.H.; Giménez, A.; Varol, H.; Tüzel, Y.; Egea-Gilabert, C.; Fernández, J.A.; Martínez-Ballesta, M.D.C. Effect of Exogenously Applied Methyl Jasmonate on Yield and Quality of Salt-Stressed Hydroponically Grown Sea Fennel (Crithmum maritimum L.). Agronomy 2021, 11, 1083. [Google Scholar] [CrossRef]
- Tarchoune, I.; Sgherri, C.; Eddouzi, J.; Zinnai, A.; Quartacci, M.F.; Zarrouk, M. Olive Leaf Addition Increases Olive Oil Nutraceutical Properties. Molecules 2019, 24, 545. [Google Scholar] [CrossRef]
- Renna, M.; Gonnella, M.; Caretto, S.; Mita, G.; Serio, F. Sea Fennel (Crithmum maritimum L.): From Underutilized Crop to New Dried Product for Food Use. Genet. Resour. Crop. Evol. 2017, 64, 205–216. [Google Scholar] [CrossRef]
- Gori, A.; Nascimento, L.B.; Ferrini, F.; Centritto, M.; Brunetti, C. Seasonal and Diurnal Variation in Leaf Phenolics of Three Medicinal Mediterranean Wild Species: What Is the Best Harvesting Moment to Obtain the Richest and the Most Antioxidant Extracts? Molecules 2020, 25, 956. [Google Scholar] [CrossRef] [PubMed]
- Dogan, H.; Uskutoglu, T.; Bas, H.; Stankov, S.; Fidan, H.; Cosge Şenkal, B.; Stoynova, A.; Petkova, N.; Yilmaz, G.; Dinacheva, I. Phytochemical Composition of Wild Lemon Balm (Melissa officinalis L.) from the Flora of Bulgaria. Ant. J. Bot. 2021, 5, 112–119. [Google Scholar] [CrossRef]
- Chatzimitakos, T.; Athanasiadis, V.; Makrygiannis, I.; Kalompatsios, D.; Bozinou, E.; Lalas, S.I. An Investigation into Crithmum maritimum L. Leaves as a Source of Antioxidant Polyphenols. Compounds 2023, 3, 532–551. [Google Scholar] [CrossRef]
- Kontogianni, V.G.; Kasapidou, E.; Mitlianga, P.; Mataragas, M.; Pappa, E.; Kondyli, E.; Bosnea, L. Production, Characteristics and Application of Whey Protein Films Activated with Rosemary and Sage Extract in Preserving Soft Cheese. LWT 2022, 155, 112996. [Google Scholar] [CrossRef]
- Lahcene, S.; Moualek, I.; Bariz, K.; Benramdane, E.; Alenazy, R.; Alqasmi, M.; Almufarriji, F.M.; Thabet, M.; Fallata, G.; Alqurainy, N.; et al. Antioxidant and Antibacterial Activities and Phytochemical Analysis of Olea europaea subsp. Laperrinei Leaves Extracts. Processes 2025, 13, 1113. [Google Scholar] [CrossRef]
- Chen, X.; Lan, W.; Xie, J. Natural Phenolic Compounds: Antimicrobial Properties, Antimicrobial Mechanisms, and Potential Utilization in the Preservation of Aquatic Products. Food Chem. 2024, 440, 138198. [Google Scholar] [CrossRef]
- Selim, S.; Albqmi, M.; Al-Sanea, M.M.; Alnusaire, T.S.; Almuhayawi, M.S.; AbdElgawad, H.; Al Jaouni, S.K.; Elkelish, A.; Hussein, S.; Warrad, M.; et al. Valorizing the Usage of Olive Leaves, Bioactive Compounds, Biological Activities, and Food Applications: A Comprehensive Review. Front. Nutr. 2022, 9, 1008349. [Google Scholar] [CrossRef]
- Yasir, M.; Nawaz, A.; Ghazanfar, S.; Okla, M.K.; Chaudhary, A.; Al, W.H.; Ajmal, M.N.; Abdelgawad, H.; Ahmad, Z.; Abbas, F.; et al. Anti-Bacterial Activity of Essential Oils against Multidrug-Resistant Foodborne Pathogens Isolated from Raw Milk. Braz. J. Biol. 2024, 84, e259449. [Google Scholar] [CrossRef]
- Al-Rimawi, F.; Sbeih, M.; Amayreh, M.; Rahhal, B.; Mudalal, S. Evaluation of the Antibacterial and Antifungal Properties of Oleuropein, Olea Europea Leaf Extract, and Thymus vulgaris Oil. BMC Complement. Med. Ther. 2024, 24, 297. [Google Scholar] [CrossRef]
- Assar, D.H.; Ragab, A.E.; Abdelsatar, E.; Salah, A.S.; Salem, S.M.R.; Hendam, B.M.; Al Jaouni, S.; Al Wakeel, R.A.; AbdEl-Kader, M.F.; Elbialy, Z.I. Dietary Olive Leaf Extract Differentially Modulates Antioxidant Defense of Normal and Aeromonas Hydrophila-Infected Common Carp (Cyprinus carpio) via Keap1/Nrf2 Pathway Signaling: A Phytochemical and Biological Link. Animals 2023, 13, 2229. [Google Scholar] [CrossRef]
- Bisignano, G.; Tomaino, A.; Cascio, R.L.; Crisafi, G.; Uccella, N.; Saija, A. On the In-Vitro Antimicrobial Activity of Oleuropein and Hydroxytyrosol. J. Pharm. Pharmacol. 2010, 51, 971–974. [Google Scholar] [CrossRef] [PubMed]
- Mimica, N.; Mekinić, I.G.; Skroza, D.; Brzović, P. Influence of Harvest Location on Phenolic Composition and Antioxidant Activity of Sea Fennel. Croat. J. Food Sci. Technol. 2024, 16, 133–143. [Google Scholar] [CrossRef]
- Lemoine, C.; Rodrigues, M.J.; Dauvergne, X.; Cérantola, S.; Custódio, L.; Magné, C. A Characterization of Biological Activities and Bioactive Phenolics from the Non-Volatile Fraction of the Edible and Medicinal Halophyte Sea Fennel (Crithmum maritimum L.). Foods 2024, 13, 1294. [Google Scholar] [CrossRef]
- Correia, I.; Antunes, M.; Tecelão, C.; Neves, M.; Pires, C.L.; Cruz, P.F.; Rodrigues, M.; Peralta, C.C.; Pereira, C.D.; Reboredo, F.; et al. Nutritive Value and Bioactivities of a Halophyte Edible Plant: Crithmum maritimum L. (Sea Fennel). Plants 2024, 13, 427. [Google Scholar] [CrossRef] [PubMed]
- Christopoulou, S.D.; Androutsopoulou, C.; Hahalis, P.; Kotsalou, C.; Vantarakis, A.; Lamari, F.N. Rosemary Extract and Essential Oil as Drink Ingredients: An Evaluation of Their Chemical Composition, Genotoxicity, Antimicrobial, Antiviral, and Antioxidant Properties. Foods 2021, 10, 3143. [Google Scholar] [CrossRef] [PubMed]
- Al Jaafreh, A.M. Evaluation of Antioxidant Activities of Rosemary (Rosmarinus officinalis L.) Essential Oil and Different Types of Solvent Extractions. Biomed. Pharmacol. J. 2024, 17, 323–339. [Google Scholar] [CrossRef]
- Valinger, D.; Kušen, M.; Benković, M.; Jurina, T.; Panić, M.; Redovniković, I.R.; Kljusurić, J.G.; Tušek, A.J. Enhancement of the Green Extraction of Bioactive Molecules from Olea europaea Leaves. Separations 2022, 9, 33. [Google Scholar] [CrossRef]
- Makowska-Wąs, J.; Galanty, A.; Gdula-Argasińska, J.; Tyszka-Czochara, M.; Szewczyk, A.; Nunes, R.; Carvalho, I.S.; Michalik, M.; Paśko, P. Identification of Predominant Phytochemical Compounds and Cytotoxic Activity of Wild Olive Leaves (Olea europaea L. ssp. sylvestris) Harvested in South Portugal. Chem. Biodivers. 2017, 14, e1600331. [Google Scholar] [CrossRef]
- Rimawi, W.H.; Salim, H. Wild versus Cultivated Olive Leaves Extracts: Antioxidant Activity, Analysis of Total Phenolics and Oleoropein Content. J. Chem. Biochem. 2016, 4, 61–88. [Google Scholar] [CrossRef]
- Draginic, N.; Andjic, M.; Jeremic, J.; Zivkovic, V.; Kocovic, A.; Tomovic, M.; Bozin, B.; Kladar, N.; Bolevich, S.; Jakovljevic, V.; et al. Anti-Inflammatory and Antioxidant Effects of Melissa officinalis Extracts: A Comparative Study. Iran. J. Pharm. Res. 2022, 21, e126561. [Google Scholar] [CrossRef]
- Szydłowska-Czerniak, A.; Kowaluk, A.; Strzelec, M.; Sawicki, T.; Tańska, M. Evaluation of Bioactive Compounds and Chemical Elements in Herbs: Effectiveness of Choline Chloride-Based Deep Eutectic Solvents in Ultrasound-Assisted Extraction. Molecules 2025, 30, 368. [Google Scholar] [CrossRef]
- Bouloumpasi, E.; Hatzikamari, M.; Christaki, S.; Lazaridou, A.; Chatzopoulou, P.; Biliaderis, C.G.; Irakli, M. Assessment of Antioxidant and Antibacterial Potential of Phenolic Extracts from Post-Distillation Solid Residues of Oregano, Rosemary, Sage, Lemon Balm, and Spearmint. Processes 2024, 12, 140. [Google Scholar] [CrossRef]
- Kozłowska, M.; Ścibisz, I.; Przybył, J.L.; Laudy, A.E.; Majewska, E.; Tarnowska, K.; Małajowicz, J.; Ziarno, M. Antioxidant and Antibacterial Activity of Extracts from Selected Plant Material. Appl. Sci. 2022, 12, 9871. [Google Scholar] [CrossRef]

| Plant Material | Extract | TPC | TFC | ||
|---|---|---|---|---|---|
| mgGAE/L | mgGAE/gplant | mgQE/L | mgQE/gplant | ||
| Sea fennel leaf | W | 648.48 ± 50.07 f | 12.97 ± 1.00 g | 122.30 ± 4.16 g | 2.45 ± 0.08 g |
| HA | 854.24 ± 2.54 e,f | 17.085 ± 0.25 e,f,g | 333.50 ± 4.69 f | 6.67 ± 0.09 f | |
| Sea fennel flower | W | 1585.58 ± 62.13 b | 31.711 ± 1.24 c | 414.09 ± 32.21 e,f | 8.28 ± 0.64 e,f |
| HA | 973.64 ± 27.74 c,d,e | 19.47 ± 0.56 d,e,f | 1794.63 ± 22.87 a | 35.89 ± 0.46 a | |
| Rosemary | W | 836.00 ± 13.83 e,f | 16.72 ± 0.28 f,g | 123.50 ± 6.95 g | 2.47 ± 0.14 g |
| HA | 3321.21 ± 189.02 a | 66.42 ± 3.78 a | 603.53 ± 19.02 c | 12.07 ± 0.38 c | |
| Olive | W | 204.55 ± 7.10 g | 4.09 ± 0.14 h | 93.70 ± 7.07 g | 1.87 ± 0.14 g |
| HA | 904.55 ± 52.20 d,e | 18.09 ± 1.04 e,f,g | 470.13 ± 43.93 d,e | 9.40 ± 0.88 d,e | |
| Mock privet | W | 1044.15 ± 34.13 c,d,e | 49.51 ± 0.68 b | 161.03 ± 16.18 g | 3.22 ± 0.32 g |
| HA | 906.97 ± 9.33 d,e | 18.14 ± 0.19 e,f,g | 771.27 ± 69.62 b | 15.43 ± 1.39 b | |
| Lemon balm | W | 1126.94 ± 28.43 c,d | 22.54 ± 3.78 d,e | 521.99 ± 9.21 c,d | 10.44 ± 0.18 c,d |
| HA | 1199.09 ± 153.52 c | 23.98 ± 3.07 d | 582.16 ± 26.16 c | 11.64 ± 0.52 c | |
| Compound | Water Extracts | Hydroalcoholic Extracts | |||||||||||
|---|---|---|---|---|---|---|---|---|---|---|---|---|---|
| Sea Fennel Leaf | Sea Fennel Flower | Rosemary | Olive | Mock Privet | Lemon Balm | Sea Fennel Leaf | Sea Fennel Flower | Rosemary | Olive | Mock Privet | Lemon Balm | ||
| Caffeic acid | mg/L extract | 1.977 ± 0.020 j,E | 6.120 ± 0.194 g,h,i,B | 0.163 ± 0.001 l,H | 3.290 ± 0.017 c,D | 1.532 ± 0.054 f,g,F | 0.139 ± 0.001 j,H | 5.205 ± 0.338 i,j,C | 6.615 ± 0.010 j,A | n.d. l,H | 5.931 ± 0.015 d,e,f,g,h,B | 2.034 ± 0.010 k,l,E | 0.604 ± 0.008 k,G |
| Coumaric acid | 10.054 ± 0.082 e,D | 65.146 ± 0.120 d,B | 0.416 ± 0.012 j,k,G,H | 0.479 ± 0.008 f,g,h,G | 0.208 ± 0.015 g,G,H,I | 0.131 ± 0.003 j,H,I | 12.219 ± 0.053 g,C | 93.357 ± 0.362 c,A | n.d. l,I | 2.149 ± 0.033 f,g,h,F | 2.538 ± 0.004 E | n.d. k,I | |
| Ellagic acid | 0.120 ± 0.000 n,o,G | 0.587 ± 0.029 i,C | 0.047 ± 0.001 m,H | 0.412 ± 0.000 g,h,E | 0.057 ± 0.002 g,H | 0.041 ± 0.011 k,H | 0.353 ± 0.002 k,F | 0.492 ± 0.000 l,D | 0.409 ± 0.002 k,l,E | 1.250 ± 0.003 g,h,A | 0.451 ± 0.003 l,m,D,E | 0.653 ± 0.043 k,B | |
| Ferulic acid | 10.695 ± 0.017 d,G | 78.958 ± 0.444 c,A | 0.826 ± 0.008 h,L | 2.157 ± 0.002 d,K | 14.680 ± 0.070 b,F | 5.097 ± 0.016 b,J | 31.376 ± 0.085 e,E | 66.872 ± 0.049 e,B | 9.463 ± 0.005 e,f,H | 7.897 ± 0.032 d,e,f,g,h,I | 55.149 ± 0.112 b,C | 42.956 ± 0.296 b,D | |
| Protocatechuic acid | 1.919 ± 0.009 j,k,G | 3.394 ± 0.057 g,h,i,F | 1.068 ± 0.053 g,H | 0.704 ± 0.001 e,f,g,h,H | 1.044 ± 0.009 j, | 1.100 ± 0.163 f,H | 8.698 ± 0.525 h,E | 15.302 ± 0.003 hA | 9.765 ± 0.009 e,D | 8.269 ± 0.439 d,e,f,g,E | 11.633 ± 0.008 g,C | 12.608 ± 0.041 e,f,B | |
| 4-hydroxybenzoic acid | 4.689 ± 0.000 h,E | 9.774 ± 0.239 g,B | 4.258 ± 0.005 d,E | 0.253 ± 0.001 g,h,H | 1.171 ± 0.027 g,G | 0.385 ± 0.019 i,H | 8.971 ± 0.591 h,C | 4.724 ± 0.238 k,E | 8.140 ± 0.000 g,D | 0.710 ± 0.005 g,h,G,H | 18.160 ± 0.005 f,A | 2.266 ± 0.023 j,F | |
| Caffeoylmalic acid | 2.669 ± 0.077 i,D | 6.083 ± 0.016 g,h,i,A | 0.335 ± 0.005 k,G | 1.475 ± 0.005 d,e,f,E | 3.001 ± 0.021 f,C | 0.869 ± 0.002 g,F | 0.763 ± 0.116 k,F | 0.339 ± 0.007 l,G | 3.856 ± 0.044 j,B | 4.004 ± 0.189 e,f,g,h,B | 2.572 ± 0.002 j,k,D | 2.504 ± 0.053 j,D | |
| Gallic acid | 1.264 ± 0.003 l,m,G | 2.738 ± 0.006 h,i,E | 0.520 ± 0.001 i,j,I | 0.925 ± 0.002 e,f,g,h,H | 1.437 ± 0.023 g,F | 0.506 ± 0.004 h,I | 3.769 ± 0.009 j,C | 3.574 ± 0.040 k,D | 2.805 ± 0.009 j,E | 3.987 ± 0.017 e,f,g,h,B | 9.254 ± 0.106 h,A | 3.484 ± 0.127 i,D | |
| Chlorogenic acid | 106.464 ± 0.475 a,D | 683.137 ± 0.105 b,B | 0.795 ± 0.002 h,I | 0.836 ± 0.001 e,f,g,h,I | 0.931 ± 0.020 g,I | 1.047 ± 0.003 f,I | 329.939 ± 0.023 b,C | 765.234 ± 0.231 b,A | 6.468 ± 0.005 h,F | 5.557 ± 0.001 d,e,f,g,h,G | 4.608 ± 0.001 i,H | 12.728 ± 0.048 e,E | |
| Rosmarinic acid | 7.760 ± 0.228 f,J | 18.022 ± 0.044 f,I | 61.369 ± 0.142 b,E | 3.887 ± 0.022 b,c,K | 4.815 ± 0.250 e,K | 107.307 ± 0.154 a,C | 49.474 ± 1.128 d,F | 74.233 ± 0.076 d,D | 326.553 ± 1.299 b,B | 21.772 ± 0.195 b,H | 36.196 ± 0.514 d,G | 1282.644 ± 1.063 a,A | |
| Vanilic acid | 2.787 ± 0.035 i,F | 5.745 ± 0.056 g,h,i,C | 3.321 ± 0.003 e,E | 0.746 ± 0.006 e,f,g,h,H | 0.185 ± 0.001 g,I | 2.497 ± 0.003 e,F | 7.494 ± 0.405 h,i,B | 1.191 ± 0.017 l,G | 12.336 ± 0.021 d,A | 3.556 ± 0.035 f,g,h,E | 5.095 ± 0.083 i,D | 2.800 ± 0.010 i,j,F | |
| Naringin | 90.838 ± 0.013 b,E | 4039.836 ± 9.638 a,A | 75.755 ± 0.007 a,F | 4.784 ± 0.022 b,J | 8.566 ± 0.033 c,J | 4.829 ± 0.047 c,J | 366.263 ± 0.735 a,C | 3228.736 ± 2.321 a,B | 337.536 ± 0.340 a,D | 21.080 ± 0.214 b,c,I | 52.622 ± 5.208 c,G | 36.116 ± 0.034 c,H | |
| Kaempferol | 1.515 ± 0.000 k,l,E | 3.475 ± 0.000 g,h,i,D | 0.384 ± 0.018 k,H | 0.540 ± 0.000 f,g,h,F | 0.442 ± 0.000 g,G | 0.520 ± 0.001 h,F | 11.856 ± 0.000 g,C | 11.861 ± 0.000 i,C | 12.222 ± 0.055 d,A | 11.932 ± 0.004 d,e,B | 11.859 ± 0.000 g,C | 11.871 ± 0.000 f,C | |
| Quercetin | 0.431 ± 0.000 n,J | 0.986 ± 0.001 i,H | 1.223 ± 0.002 f,G | 0.489 ± 0.002 f,g,h,I | 0.238 ± 0.000 g,L | 0.400 ± 0.001 i,K | 3.390 ± 0.000 j,F | 3.506 ± 0.001 k,D | 8.908 ± 0.002 e,f,g,A | 3.400 ± 0.000 f,g,h,E | 3.773 ± 0.002 i,j,k,C | 7.303 ± 0.011 h,B | |
| Myricetin | 0.057 ± 0.001 n,o,F | 8.938 ± 0.002 g,h,B | 0.962 ± 0.006 g,E | 2.170 ± 0.001 d,D | 0.728 ± 0.001 g,E | n.d. k,F | 13.514 ± 0.062 g,F | 0.972 ± 0.019 l,E | 8.691 ± 0.075 f,g,B | 8.643 ± 0.013 d,e,f,g,B | 4.413 ± 0.465 i,j,C | n.d. k,F | |
| Quercetin-3-glucoside | 6.897 ± 0.042 g,H | 45.744 ± 0.256 e,B | 0.557 ± 0.004 i,F | 1.618 ± 0.197 d,e,J | 6.788 ± 0.009 d,H | 2.899 ± 0.009 d,J | 26.580 ± 0.218 f,E | 48.338 ± 0.012 f,A | 12.570 ± 0.058 d,F | 10.292 ± 0.034 d,e,f,G | 36.809 ± 0.211 d,C | 31.230 ± 0.243 d,D | |
| Rutin trihydrate | 1.058 ± 0.030 m,E | 4.050 ± 0.047 g,h,i,D | 0.221 ± 0.001 l,F | 0.757 ± 0.001 e,f,g,h,E,F | 0.339 ± 0.004 g,E,F | 0.390 ± 0.013 i,E,F | 7.992 ± 0.849 h,C | 7.355 ± 0.002 j,C | 9.486 ± 0.021 e,f,B | 9.711 ± 0.054 d,e,f,A,B | 9.374 ± 0.018 h,B | 10.313 ± 0.093 g,A | |
| Oleuropein | 14.682 ± 0.264 c,H | 66.914 ± 1.575 d,F | 4.697 ± 0.049 c,H,I | 556.738 ± 1.503 a,C | 325.065 ± 2.251 a,D | 0.795 ± 0.028 g,I | 144.881 ± 3.039 c,E | 37.420 ± 0.803 g,G | 15.091 ± 0.117 c,H | 2004.922 ± 12.079 a,B | 2318.626 ± 0.264 a,A | 7.201 ± 0.140 h,H,I | |
| Luteolin | n.d. o,E | 0.042 ± 0.001 i,E | 0.562 ± 0.001 i,D | 1.223 ± 0.001 d,e,f,g,B | 0.700 ± 0.010 g,C | 0.023 ± 0.000 k,E | n.d. k,E | n.d. l,E | n.d. l,E | n.d. h,E | 2.324 ± 0.159 k,l,A | 0.669 ± 0.003 k,C,D | |
| Apigenin | n.d. o,F | 1.388 ± 0.017 i,B | 0.211 ± 0.004 l,D | 0.068 ± 0.000 h,E | 0.055 ± 0.000 g,F | n.d. k,F | n.d..k,F | n.d. l,F | 1.264 ± 0.003 k,C | n.d. h,F | n.d. m,F | 2.055 ± 0.018 j,A | |
| Carvacrol | n.d. o,D | n.d. i,D | n.d. m,D | n.d. h,D | n.d. g,D | n.d. k,D | n.d. k,D | 10.771 ± 0.373 i,C | n.d. l,D | 13.423 ± 0.244 c,d,B | 30.017 ± 1.282 e,A | n.d. k,D | |
Disclaimer/Publisher’s Note: The statements, opinions and data contained in all publications are solely those of the individual author(s) and contributor(s) and not of MDPI and/or the editor(s). MDPI and/or the editor(s) disclaim responsibility for any injury to people or property resulting from any ideas, methods, instructions or products referred to in the content. |
© 2025 by the authors. Licensee MDPI, Basel, Switzerland. This article is an open access article distributed under the terms and conditions of the Creative Commons Attribution (CC BY) license (https://creativecommons.org/licenses/by/4.0/).
Share and Cite
Babić, P.; Cvetnić, T.S.; Čanak, I.; Dujmović, M.; Semenčić, M.Č.; Šupljika, F.; Vranješ, Z.; Debeaufort, F.; Benbettaieb, N.; Descours, E.; et al. Properties of Plant Extracts from Adriatic Maritime Zone for Innovative Food and Packaging Applications: Insights into Bioactive Profiles, Protective Effects, Antioxidant Potentials and Antimicrobial Activity. Antioxidants 2025, 14, 906. https://doi.org/10.3390/antiox14080906
Babić P, Cvetnić TS, Čanak I, Dujmović M, Semenčić MČ, Šupljika F, Vranješ Z, Debeaufort F, Benbettaieb N, Descours E, et al. Properties of Plant Extracts from Adriatic Maritime Zone for Innovative Food and Packaging Applications: Insights into Bioactive Profiles, Protective Effects, Antioxidant Potentials and Antimicrobial Activity. Antioxidants. 2025; 14(8):906. https://doi.org/10.3390/antiox14080906
Chicago/Turabian StyleBabić, Petra, Tea Sokač Cvetnić, Iva Čanak, Mia Dujmović, Mojca Čakić Semenčić, Filip Šupljika, Zoja Vranješ, Frédéric Debeaufort, Nasreddine Benbettaieb, Emilie Descours, and et al. 2025. "Properties of Plant Extracts from Adriatic Maritime Zone for Innovative Food and Packaging Applications: Insights into Bioactive Profiles, Protective Effects, Antioxidant Potentials and Antimicrobial Activity" Antioxidants 14, no. 8: 906. https://doi.org/10.3390/antiox14080906
APA StyleBabić, P., Cvetnić, T. S., Čanak, I., Dujmović, M., Semenčić, M. Č., Šupljika, F., Vranješ, Z., Debeaufort, F., Benbettaieb, N., Descours, E., & Kurek, M. (2025). Properties of Plant Extracts from Adriatic Maritime Zone for Innovative Food and Packaging Applications: Insights into Bioactive Profiles, Protective Effects, Antioxidant Potentials and Antimicrobial Activity. Antioxidants, 14(8), 906. https://doi.org/10.3390/antiox14080906

